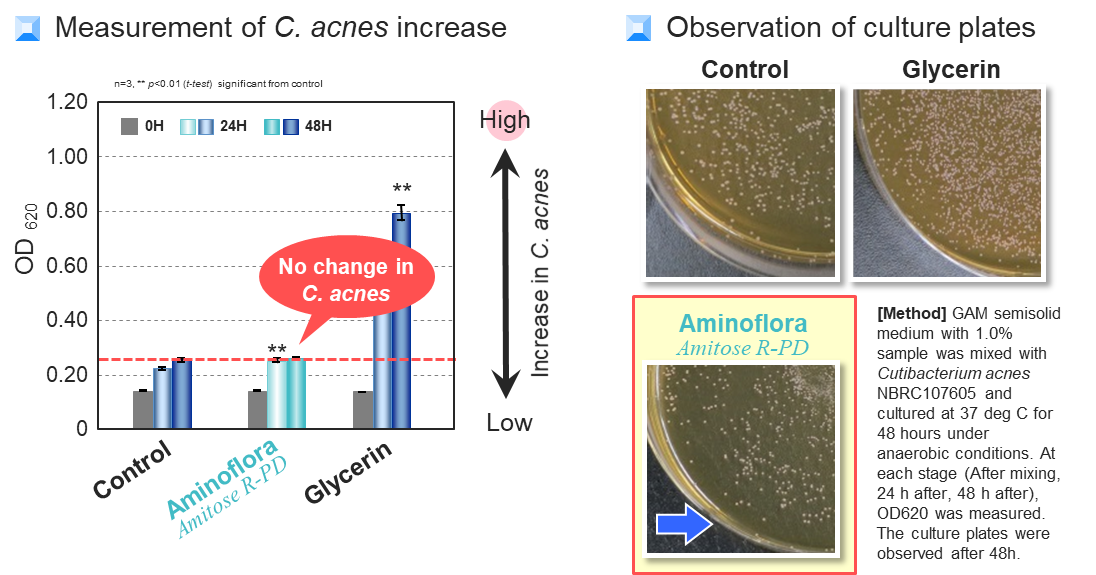

In recent years, scientific research has shed light on a fascinating aspect of our skin's ecosystem: the microbiome. The skin microbiome, a complex community of microorganisms residing on the skin's surface, has proven to play a pivotal role in maintaining skin health. This article aims to highlight the significance of a balanced microbiome for vibrant and youthful skin.
There are more than 1,000 species of microorganisms on the skin, and the composition of the skin microbiome depends on individuals and it changes daily. Imbalances and reductions in the diversity of the skin's resident microorganisms can lead to skin problems. SEIWA KASEI has developed a new type of amino acid derivative named “Aminoflora” to improve the microbiome of the skin. The product name of Aminoflora is Amitose™ R-PD.
Aminoflora was developed by combining two molecules, Glycerin and Arginine, through our patented technology. This ingredient can provide balance to skin microbiome and improve skin condition.

Property
- Long-lasting moisturising Effect in both hair care and skin care.
- Skin Microbiome Care “Aminoflora”
- Scalp treatment effect, can prevent dandruff and relieve scalp itching.
The skin microbiome
The skin microbiome is incredibly diverse and consists of various types of bacteria, fungi, viruses, and other microorganisms. There are three typical skin resident microorganisms on the skin: opportunistic, good and bad microorganisms. We generally believe that the more good microorganisms the better, while the fewer bad microorganisms the better. Aminoflora approaches the improvement of the skin microbiome by selectively increasing the good microorganisms for beautiful skin and not affecting the opportunistic/bad microorganisms. There are many approaches to improving the skin microbiome, and Aminoflora targets the“Utilisation” to achieve it.

Utilisation test
“Utilisation” is a biological phenomenon in that a given substance is used as a nutrient by microorganisms which as a consequence proliferate. In general, if the substances present on the skin provide nourishment or a favourable environment for good microorganisms, it can contribute to maintaining a healthy skin microbiome. The presence of substances that promote the growth of bad/opportunistic microorganisms on the skin can disrupt the balance of the skin microbiome and potentially lead to various skin issues and conditions. We have conducted experiments using different types of microorganisms to verify the effectiveness of Aminoflora in regulating the balance of the skin microbiome.
Opportunistic microorganisms
Cutibacterium acnes, acne-causing bacteria. They help the skin to keep its good condition. Nevertheless, when they grow too much, they cause inflammation and induce acne. Aminoflora can’t be utilised by C. acnes, so risks of acne are minimised.
Good microorganisms
Staphylococcus epidermidis, bacteria found in number on healthy skin. They keep the skin slightly acidic and produce anti-bacterial substances which prevent the proliferation of bad bacteria such as S. aureus. Aminoflora can be utilised by S. epidermidis and multiplies it, leading to beautiful skin.

Bad microorganisms
Staphylococcus aureus is, a bacteria found in numbers on rough skin. When some skin troubles make the skin more alkaline, they multiply and worsen the troubles leading to inflammation. Aminoflora can’t be utilised by S. aureus, so it does not affect skin troubles or deterioration.

Bad microorganisms (For scalp)
Malassezia furfur, bacteria that cause seborrheic dermatitis and dandruff. They are lipophilic fungus that uses sebum as its nutrient source and proliferates in proportion to the increase in sebum secretion. Aminoflora can’t be utilised by M. furfur which induces dandruff.

As our understanding of the skin microbiome deepens, it becomes clear that nurturing a balanced microbial community is vital for optimal skin health. By embracing high-functioning products like Aminoflora, individuals can unlock the secrets to radiant and revitalised skin, all while supporting the delicate harmony of their skin microbiome.

